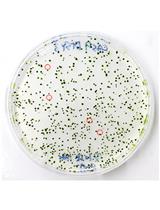
利用CRISPR技术对莱茵衣藻进行DNA-free的基因组编并对产生突变进行分析

发布: 2016年07月05日第6卷第13期 DOI: 10.21769/BioProtoc.1854 浏览次数: 12931
评审: Arsalan DaudiRainer MelzerAnonymous reviewer(s)
Abstract
Relative chromosome dosage, i.e., increases or decreases in the number of copies of specific chromosome regions in one sample versus another, can be determined using aligned read-counts from Illumina sequencing (Henry et al., 2010). The following protocol was used to identify the different classes of aneuploids that result from uniparental genome elimination in Arabidopsis thaliana, including chromosomes that have undergone chromothripsis (Tan et al., 2015). Uniparental genome elimination results in the production of haploid progeny from crosses to specific strains called “haploid inducers” (Ravi et al., 2014). On the other hand, chromothripsis, which was first discovered in cancer genomes, is a phenomenon that results in clustered, highly rearranged chromosomes. In plants, chromothripsis has been observed as a result of genome elimination (Tan et al., 2015). Detecting variation in chromosome dosage has multiple applications beside those linked to genome elimination. For example, a dosage variant population of poplar hybrids was created by gamma-irradiation of pollen grains. Hundreds of dosage lesions, insertions and deletions, were identified using this technique and provide a way to associate loci with the phenotypic consequences observed in this population (Henry et al., 2015).
This method has been successfully used to detect changes in chromosome dosage in many different species, including Arabidopsis thaliana (Tan et al., 2015), Arabidopsis suecica (Ravi et al., 2014), rice (Henry et al., 2010) and poplar (Henry et al., 2015). It is important to note that dosage plots always indicate dosage variation relative to the control sample used (Note 1). Therefore, this approach is not suitable to detect ploidy variants (diploid vs triploid, for example). Similarly, this technique does not allow the detection of balanced chromosomal rearrangements such as reciprocal translocations.
Materials and Reagents
Equipment
Software
Procedure
Representative data

Figure 1. Example dosage plot of a diploid (Sample 1) and a primary Chr3 trisomic (2n + 1) aneuploid (Sample 2) from Arabidopsis thaliana, based on a 100 kb bin size. Relative centromere positions are indicated by red diamonds. The noisy area around the pericentromeric regions of the trisomic Chr3 is due to increased Col-0:Ler ratio (2:1) of the trisomic chromosome when normalized to a diploid control that contains 50% Col-0 (or 1:1 Col-0:Ler). This variability is absent from the 50% Col-0:Ler diploid individual (Sample 1). Reviewing multiple individuals from the same dataset can identify regions with such variation.

Figure 2. Dosage plot analysis on a shattered aneuploid Chr1 from Arabidopsis thaliana divided in 50 kb bins (each dot represents a bin) and using variable number of reads as input: 250,000 reads (top), 1 million reads (middle) and 4 million reads (bottom). This data illustrates how increased read count is necessary for the detection of smaller dosage variations. For species with bigger genome sizes, the number of reads necessary to obtain a similar level of detection increases accordingly. Similarly, for polyploid genomes, read coverage has to be higher to compensate for the relatively smaller increase or decrease in copy number in a higher ploidy background (Figure 3).

Figure 3. Effect of polyploidy on dosage variation detection. Using data from gamma-irradiated poplar, we created an in silico "dilution series" of the signal originating from a deletion event. Reads from a diploid individual carrying a heterozygous deletion were pooled with increasing numbers of reads from a control diploid individual, to model the decrease in coverage expected from the loss of one copy out of a starting ploidy-level ranging from 2 to 12 (y-axis).
Notes
Acknowledgments
This work was funded by HHMI and the Gordon and Betty Moore Foundation (GBMF) through grant GBMF3068 to L.C. and by the DOE Office of Science, Office of Biological and Environmental Research (BER), grants no. DE-SC0007183 (to L.C. and I.M.H.). This protocol was adapted from Tan et al. (2015).
References
文章信息
版权信息
Tan et al. This article is distributed under the terms of the Creative Commons Attribution License (CC BY 4.0).
如何引用
Readers should cite both the Bio-protocol article and the original research article where this protocol was used:
分类
植物科学 > 植物分子生物学 > DNA > DNA 测序
系统生物学 > 基因组学 > 测序
系统生物学 > 基因组学 > 功能基因组学
您对这篇实验方法有问题吗?
在此处发布您的问题,我们将邀请本文作者来回答。同时,我们会将您的问题发布到Bio-protocol Exchange,以便寻求社区成员的帮助。
Share
Bluesky
X
Copy link